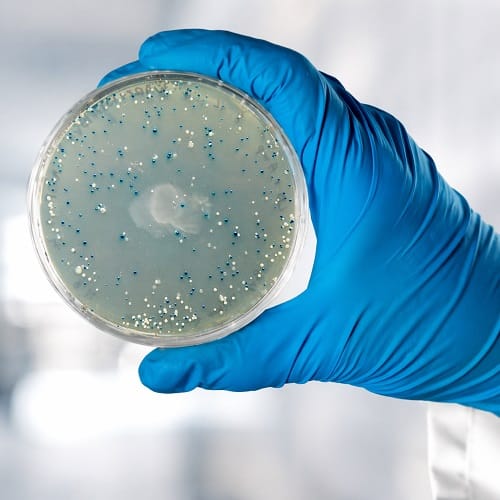
transformacion

At Tiaris Education, we believe that the best way to understand science is to experience it. Our Educational Kits are designed to bring real molecular biology into the classroom through hands-on, engaging, and safe experiments that spark curiosity and inspire the next generation of scientists.
Tiaris Educational Kits are built to be intuitive, exciting, and adaptable to a variety of learning environments. From DNA extraction to forensic PCR investigations, our goal is to make biotechnology accessible, interactive, and inspiring.
Empower your classroom with Tiaris Education.



| Ref. | Product name | Format | Price |
| TBED30-20 | Blood Genomic DNA Purification Kit | 20 reactions | 60 € |
| TBED31-20 | Blood Genomic DNA Purification Kit-Plus | 20 reactions | 76 € |
The Blood Genomic DNA Purification Kit is designed for the efficient isolation of high-quality genomic DNA from whole blood samples. This kit provides a simple and reliable workflow, making it ideal for educational settings where students can learn fundamental DNA extraction techniques from clinically relevant sample types.
Kit includes all necessary reagents for DNA extraction and purification, along with a detailed protocol optimized for classroom use.
The TBED30-21 reference also includes additional components for DNA analysis by gel electrophoresis, such as agarose, electrophoresis buffer, DNA loading dye, and DNA stain.
Suitable for 10–12 students.
The TBED30-21 reference also includes additional components for DNA analysis by gel electrophoresis, including:
Student Guide, Blood DNA Extraction
| Ref. | Product name | Format | Price |
| TBED33-20 | Buccal Swab Genomic DNA Purification Kit | 20 reactions | 65 € |
| TBED34-20 | Buccal Swab Genomic DNA Purification Kit-Plus | 20 reactions | 80 € |
The Buccal Swab Genomic DNA Purification Kit is designed for the efficient isolation of high-quality genomic DNA from buccal (cheek) cells collected using non-invasive swabs. This kit provides a simple and reliable workflow, making it ideal for educational settings where students can learn fundamental DNA extraction techniques using their own samples.
Kit includes all necessary reagents for DNA extraction and purification, along with buccal swabs for sample collection and a detailed protocol optimized for classroom use.
The TBED34-20 reference also includes additional components for DNA analysis by gel electrophoresis, such as agarose, electrophoresis buffer, DNA loading dye, and DNA stain.
Suitable for 10–12 students.
The TBED34-20 reference also includes additional components for DNA analysis by gel electrophoresis, including:
Student Guide, Buccal Swab DNA Extraction
| Ref. | Product name | Format | Price |
| TBED42-20 | Tissue Genomic DNA Purification Kit | 20 reactions | 64 € |
| TBED36-20 | Tissue Genomic DNA Purification Kit-Plus | 20 reactions | 78€ |
The Tissue Genomic DNA Purification Kit is designed for the efficient isolation of high-quality genomic DNA from animal tissue samples. This kit enables students to explore DNA extraction from solid biological materials using a robust and reproducible workflow.
Kit includes all necessary reagents for DNA extraction and purification, along with buccal swabs for sample collection and a detailed protocol optimized for classroom use.
The TBED36-20 reference also includes additional components for DNA analysis by gel electrophoresis, such as agarose, electrophoresis buffer, DNA loading dye, and DNA stain.
Suitable for 10–12 students.
The TBED36-20 reference also includes additional components for DNA analysis by gel electrophoresis, including:
Student Guide, Tissue DNA Extraction
| Ref. | Product name | Format | Price |
| TBED40-20 | Plasmid DNA Purification Kit | 20 reactions | 48 € |
| TBED38-20 | Plasmid DNA Purification Kit-Plus | 20 reactions | 62 € |
The Plasmid DNA Purification Kit is designed for the isolation of high-quality plasmid DNA from bacterial cultures. This kit allows students to learn essential molecular biology techniques related to plasmid extraction and downstream applications such as cloning and transformation.
Kit includes all necessary reagents for plasmid DNA extraction and purification, along with a detailed protocol optimized for classroom use..
The TBED38-20 reference also includes additional components for DNA analysis by gel electrophoresis, such as agarose, electrophoresis buffer, DNA loading dye, and DNA stain.
Suitable for 10–12 students.
The TBED38-20 reference also includes additional components for DNA analysis by gel electrophoresis, including:
Student Guide, Plasmid DNA Extraction
| Ref. | Product name | Format | Price |
| TBED13-20 | DNA Recovery from Agarose Gel Kit | 20 reactions | 48 € |
| TBED12-20 | DNA Recovery from Agarose Gel Kit-Plus | 20 reactions | 62 € |
DNA Recovery from Agarose Gel Kitis an easy silica-membrane-based DNA purification kit suitable for the purification of DNA embedded in agarose gels.
The TBED12-20 reference also includes additional components for DNA analysis by gel electrophoresis, such as agarose, electrophoresis buffer, DNA loading dye, and DNA stain.
Suitable for 10–12 students.
BQ Buffer
BCL1 Buffer
BQ2 Buffer
Elution Buffer
COBALT™ DNA Loading Buffer 6x
The TBED12-20 reference also includes additional components for DNA analysis by gel electrophoresis, including:
Student Guide
| Ref. | Product name | Format | Price |
| TBED32-20 | MAG-Blood Genomic DNA Purification Kit | 20 reactions | 62 € |
The Blood Genomic DNA Purification Kit is designed for the efficient isolation of high-quality genomic DNA from whole blood samples. This kit provides a simple and reliable workflow, making it ideal for educational settings where students can learn fundamental DNA extraction techniques from clinically relevant sample types.
Kit includes all necessary reagents for DNA extraction and purification, along with a detailed protocol optimized for classroom use.
Suitable for 10–12 students.
Student Guide, Blood DNA Extraction
| Ref. | Product name | Format | Price |
| TBED35-20 | MAG-Buccal Swab Genomic DNA Purification Kit | 20 reactions | 65 € |
The Buccal Swab Genomic DNA Purification Kit is designed for the efficient isolation of high-quality genomic DNA from buccal (cheek) cells collected using non-invasive swabs. This kit provides a simple and reliable workflow, making it ideal for educational settings where students can learn fundamental DNA extraction techniques using their own samples.
Kit includes all necessary reagents for DNA extraction and purification, along with buccal swabs for sample collection and a detailed protocol optimized for classroom use.
Suitable for 10–12 students.
Student Guide, Buccal Swab DNA Extraction
| Ref. | Product name | Format | Price |
| TBED37-20 | MAG-Tissue Genomic DNA Purification Kit | 20 reactions | 64 € |
The Tissue Genomic DNA Purification Kit is designed for the efficient isolation of high-quality genomic DNA from animal tissue samples. This kit enables students to explore DNA extraction from solid biological materials using a robust and reproducible workflow.
Kit includes all necessary reagents for DNA extraction and purification, along with buccal swabs for sample collection and a detailed protocol optimized for classroom use.
Suitable for 10–12 students.
Student Guide, Tissue DNA Extraction
| Ref. | Product name | Format | Price |
| TBED39-20 | MAG-Plasmid DNA Purification Kit | 20 reactions | 48 € |
The Plasmid DNA Purification Kit is designed for the isolation of high-quality plasmid DNA from bacterial cultures. This kit allows students to learn essential molecular biology techniques related to plasmid extraction and downstream applications such as cloning and transformation.
Kit includes all necessary reagents for plasmid DNA extraction and purification, along with a detailed protocol optimized for classroom use..
Suitable for 10–12 students.
Student Guide, Plasmid DNA Extraction

| Ref. | Product name | Format | Price |
| TBED30-20 | Rh Factor PCR Kit | 20 reactions | 60 € |
| TBED31-20 | Rh Factor PCR Kit-Plus | 20 reactions | 76 € |
The Rh Factor PCR Kit is designed to introduce students to DNA amplification using polymerase chain reaction (PCR) through the detection of genetic markers associated with blood group typing. This kit provides a hands-on experience in molecular diagnostics, allowing students to understand how PCR is used in real-world applications.
Kit includes all necessary reagents for PCR setup, along with a detailed protocol optimized for classroom use.
The TBED31-20 reference also includes additional components for DNA analysis by gel electrophoresis, such as agarose, electrophoresis buffer, DNA loading dye, and DNA stain.
Suitable for 10–12 students.
The TBED31-20 reference also includes additional components for DNA analysis by gel electrophoresis, including:
Student Guide
| Ref. | Product name | Format | Price |
| TBED33-20 | Plant Extract PCR Kit | 20 reactions | 65 € |
| TBED34-20 | Plant Extract PCR Kit | 20 reactions | 80 € |
The Plant Extract PCR Kit is designed to introduce students to DNA amplification from plant-derived samples using polymerase chain reaction (PCR). This kit allows students to work with plant DNA extracts and understand how PCR is applied in plant biology and research.
Kit includes all necessary reagents for PCR setup, along with a detailed protocol optimized for classroom use.
The TBED34-20 reference also includes additional components for DNA analysis by gel electrophoresis, such as agarose, electrophoresis buffer, DNA loading dye, and DNA stain.
Suitable for 10–12 students.
The TBED34-20 reference also includes additional components for DNA analysis by gel electrophoresis, including:
Student Guide
| Ref. | Product name | Format | Price |
| TBED42-20 | Standard PCR | 20 reactions | 64 € |
| TBED36-20 | Standard PCR | 20 reactions | 78€ |
The Standard PCR Workflow Kit is designed to provide a comprehensive introduction to DNA amplification using polymerase chain reaction (PCR). This kit enables students to learn the fundamental steps of PCR setup and execution in a controlled and reproducible manner.
Kit includes all necessary reagents for PCR setup, along with a detailed protocol optimized for classroom use.
The [REFERENCE] also includes additional components for DNA analysis by gel electrophoresis, including agarose, electrophoresis buffer, DNA loading dye, and DNA stain.
Suitable for 10–12 students.
The TBED36-20 reference also includes additional components for DNA analysis by gel electrophoresis, including:
Student Guide
| Ref. | Product name | Format | Price |
| TBED40-20 | Multiplex PCR Kit | 20 reactions | 48 € |
| TBED38-20 | Multiplex PCR Kit | 20 reactions | 62 € |
The Multiplex PCR Kit is designed to introduce students to the simultaneous amplification of multiple DNA targets in a single PCR reaction. This kit allows students to explore advanced PCR techniques and understand how multiplexing is used in research and diagnostics.
Kit includes all necessary reagents for multiplex PCR setup, along with a detailed protocol optimized for classroom use.
The TBED38-20 reference also includes additional components for DNA analysis by gel electrophoresis, such as agarose, electrophoresis buffer, DNA loading dye, and DNA stain.
Suitable for 10–12 students.
The TBED38-20 reference also includes additional components for DNA analysis by gel electrophoresis, including:
Student Guide
| Ref. | Product name | Format | Price |
| TBED55-24 | DNA Detectives: Identify the Suspect (STR PCR) Kit | 24 reactions | 68 € |
The DNA Detectives: Identify the Suspect (STR PCR) Kit is designed to introduce students to forensic DNA analysis using short tandem repeat (STR) amplification. This kit simulates a real forensic investigation, allowing students to compare DNA profiles and identify a suspect based on genetic evidence.
Kit includes all necessary reagents for STR PCR setup, along with a detailed protocol optimized for classroom use. The kit also provides components for DNA analysis by gel electrophoresis, enabling students to visualize and compare DNA banding patterns.
Suitable for one class group of up to 24 students, with materials for 2 gel runs.
The TBED34-20 reference also includes additional components for DNA analysis by gel electrophoresis, including:
Student Guide

| Ref. | Product name | Format | Price |
| TBED10 | Agarose Gel Electrophoresis Kit (Basic) | 50-70 gels | 170 € |
The Agarose Gel Electrophoresis Kit is designed to introduce students to the separation and visualization of DNA fragments using agarose gel electrophoresis. This kit provides a hands-on experience with one of the most widely used techniques in molecular biology laboratories.
Kit includes all necessary reagents for gel preparation and DNA visualization, along with a detailed protocol optimized for classroom use.
Suitable for 10–12 students.
Student Guide.
| Ref. | Product name | Format | Price |
| TBED17-20 | Plasmid DNA Restriction Digest Kit | 20 reactions | 240 € |
| TBED16-20 | Plasmid DNA Restriction Digest Kit-Plus | 20 reactions | 255 € |
The Plasmid DNA Restriction Digest Kit is designed to introduce students to plasmid DNA analysis using restriction enzymes. This kit provides a hands-on experience in enzymatic DNA digestion, allowing students to understand how specific enzymes cut DNA at defined sequences and how this strategy is used in molecular biology for DNA analysis and characterization.
Kit includes all necessary reagents for plasmid DNA restriction digestion, along with a detailed protocol optimized for classroom use.
The TBED16-20 reference also includes additional components for DNA analysis by gel electrophoresis, including agarose, electrophoresis buffer, DNA stain, and a DNA size marker.
Suitable for 10–12 students.
The TBED16-20 reference also includes additional components for DNA analysis by gel electrophoresis, including:
Student Guide
| Ref. | Product name | Format | Price |
| TBED24-20 | TA Cloning Kit | 20 reactions | 165 € |
The TA Cloning Kit is designed to introduce students to the fundamentals of DNA cloning using a simple TA cloning strategy. This kit provides a hands-on experience in the ligation of a DNA insert into a linear cloning vector, allowing students to understand key concepts in recombinant DNA technology and molecular cloning workflows.
Kit includes all necessary reagents for TA cloning, along with a detailed protocol optimized for classroom use.
Suitable for 10–12 students.
Student Guide
| Ref. | Product name | Format | Price |
| TBED25-20 | Competent Cell Preparation & Transformation Kit | 20 reactions | 85 € |
The Competent Cell Preparation & Transformation Kit is designed to introduce students to bacterial transformation and the preparation of competent cells using E. coli. This kit provides a practical workflow for DNA uptake by bacterial cells and allows students to understand the principles of transformation, selection, and blue-white screening in molecular biology.
Kit includes all necessary reagents and materials for competent cell preparation, bacterial transformation, and colony selection, along with a detailed protocol optimized for classroom use.
Suitable for 10–12 students.
Student Guide
| Ref. | Product name | Format | Price |
| TBED23-20 | Cloning & Transformation in E. coli Kit | 20 reactions | 225 € |
The Cloning & Transformation in E. coli Kit is designed to provide students with a complete introduction to recombinant DNA technology by combining TA cloning and bacterial transformation in a single workflow. This kit allows students to perform DNA ligation, transform E. coli cells, and analyze the results through colony selection, offering a comprehensive hands-on experience in molecular cloning.
Kit includes all necessary reagents for TA cloning, together with the materials required for competent cell preparation, bacterial transformation, and colony selection, along with a detailed protocol optimized for classroom use.
Suitable for 10–12 students.
Student Guide
